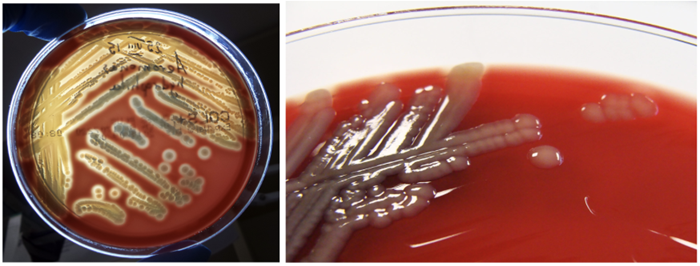
Colonies of Aeromonas hydrophila and a close-up of Aeromonas hydrophila colonies
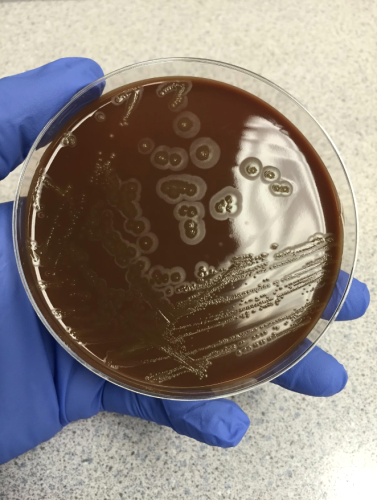
Eikenella corrodens colonies on chocolate agar.
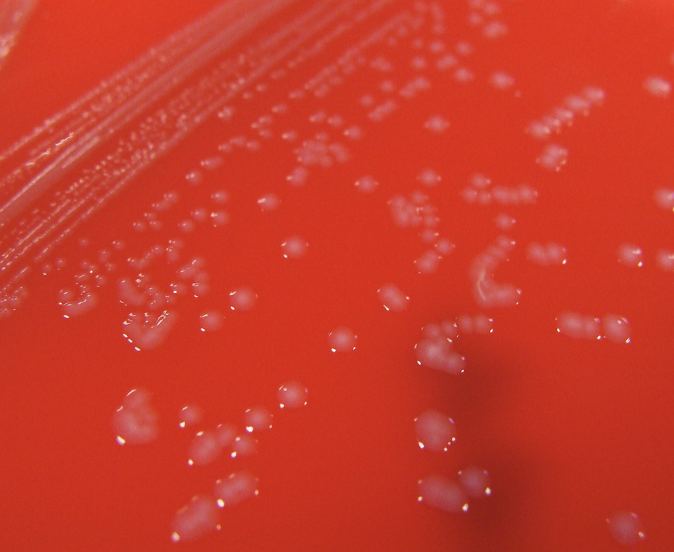
Pasteurella multocida colonies on blood agar.

The Importance of a Patient History in Clinical Microbiology: A Survival Guide to Presumptive Diagnoses
Advancements in technology like mass spectrometry, PCR and whole genome sequencing have given clinical microbiologists the power to identify organisms more efficiently and with better accuracy. While these technological developments are crucial to providing excellent patient care, they are quickly replacing traditional microbiological methods that may still be useful, easy to perform and cost effective.
While new testing methodologies may provide an answer faster, the clinician and clinical microbiologist must also have a strong understanding of which pathogen to expect based on the patient history. Why? The patient history provides an idea of which pathogen may cause infection and allows the microbiologist to optimize culture and identification methods, as well as interpret results from more advanced tests like MALDI-TOF MS and PCR. In fact, obtaining a patient history is so important, it may be possible for a microbiologist to identify the cause of an infection based on the patient history and only a few simple microbiological tests.
It is the clinician's job to produce a differential diagnosis, and the microbiologist's job to identify the suspected pathogen and its antibiotic susceptibility profile using diagnostic methods and existing knowledge of the pathogen and its respective characteristics.Medical laboratory professionals provide up to 70% of al laboratory medicine data for a physician / clinician to make an accurate diagnosis and treatment plan.
Patients With a History of Fresh Water Exposure
Patient History Example: A teenage patient presents with a necrotic leg wound after a jet-skiing accident in a lake.
When a patient presents with a wound infection after any sort of fresh water exposure, one pathogen should come to the front of a microbiologist's mind: Aeromonas. Members of this genus have been isolated from just about every type of water source including fresh water, brackish water, drinking water and polluted water. If the patient experienced a traumatic extremity injury that was exposed to one of these water sources, Aeromonas is a likely culprit. Additionally, any history of the medicinal application of leeches should be a big red Aeromonas flag for the microbiologist! Leeches are always colonized with Aeromonas bacteria because it helps them digest their blood meal, so applying leeches to wounds also comes with the risk of Aeromonas infection. Given this historical information, the microbiologist should look for the following characteristics in culture:
Gram Stain: Gram-negative rod

Growth on solid media: A wet and sometimes spreading colony on blood agar. >90% of isolates are beta hemolytic. Non-lactose fermenter on MacConkey agar.
Simple spot tests: Aeromonas species are oxidase positive.
How you know it isn't Pseudomonas aeruginosa: When isolates of P. aeruginosa are placed under a UV light, they fluoresce. Aeromonas does not. Additionally, Aeromonas ferments glucose and P. aeruginosa does not.
How this presumptive identification can help the clinician: Many general assumptions about the susceptibility patterns of Aeromonas can be made, and the susceptibility profile of this group has not seemed to change much from what was published in the 1980s and 1990s. Clinicians can use this existing published data to guide treatment and withhold unnecessary treatment with anti-pseudomonal drugs.
Other fresh and brackish water organisms to consider: Edwardsiella tarda, Erysipelothrix spp., Vibrio vulnificus and Mycobacterium marinum.
Patients With a History of Salt-Water Exposure
Patient History Example: A diabetic woman presents with a rapidly progressive foot and leg infection. She denies any unusual exposures but reports swimming in the ocean and walking on the beach with bare feet. Her blood cultures are positive.
Although infection with Vibrio vulnificus is relatively rare in the United States, the organism is a natural inhabitant of coastal waters and can cause life-threatening infections. Additionally, Vibrio is a salt-loving organism and should be suspected when the patient has a history of salt-water introduction to a wound. The consumption of raw oysters is also associated with Vibrio infection, particularly with V. vulnificus.
Gram Stain: Curved Gram-negative rod

How the patient history helps the microbiologist: If the microbiologist suspects Vibrio given a history of salt-water exposure, they can add selective media that encourages Vibrio to grow while suppressing the growth of other pathogens. These selective media types may contain salt, bile or various antibiotics to select for Vibrio species. Adding appropriate selective and differential media on day one leads to more successful organism isolation and identification.
Simple spot test: Vibrio species are oxidase positive.
How to know it is not Pseudomonas or Aeromonas: The Gram stain of Vibrio species will typically be curved. If the Gram stain shows a curved Gram-negative rod, the microbiologist can be sure the organism is not Aeromonas, Plesiomonas or Pseudomonas, which all are straight Gram-negative rods. Additionally, the use of selective media such as the thiosulfate citrate bile salts sucrose (TCBS) medium will select for Vibrio, since the presence of salt encourages its growth, while bile and high pH suppress growth of other organisms.
How this presumptive identification can help the clinician: Vibrio infections require aggressive treatment that may include debridement of wounds. Appropriate antibiotics should be started immediately if the organism is suspected. Literature shows that the susceptibility patterns for V. vulnificus are predictable for several drugs, so identification may be equally helpful as susceptibility results in this case.
Other Salt-water organisms to consider: V. parahaemolyticus, S. aureus.
Patients Who Have Been Bitten
The pathogens that cause bite wound infections are so strongly correlated with their exposure histories, the microbiologist will know exactly what to look for after hearing the patient history!
Dog or cat bites: Think Pasteurella multocida. This organism is a major cause of wound infections following animal bites, licks or scratches, particularly by dogs and cats. Unfortunately, this organism can be overlooked as a pathogen, regardless of its potential to cause serious soft tissue infections. Pasteurella is a part of the normal flora in several animals, including dogs and cats.
Other Organisms to Consider Associated with Dog/Cat Bites:

Human bites: After hearing of a human bite exposure (often in the case of children/angry siblings) or hand contact with human teeth (as in the case of bar fights in adults), the microbiologist should immediately think of Eikenella corrodens. It is important for the microbiologist to suspect this organism, as it is slow-growing and could be missed in culture.
Eikenella is a member of the HACEK group of organisms and Pasteurella is a part of the Pasteurellaceae order. Both of these organisms can be found as normal oral flora in humans and animals, respectively.
Gram Stain: Both organisms are very small, short, Gram-negative rods. They may be more commonly referred to as Gram-negative coccobacilli.
Growth on solid media: Eikenella is very distinct on solid media, particularly chocolate agar. The colonies will have a distinct smell of bleach, and each colony typically has a dry "spreading" halo around it.
Simple spot test: Both Eikenella corrodens and Pasteurella multocida are oxidase positive.
Pasteurella colonies are typically small, gray and wet in appearance.
How this presumptive identification helps the clinician: A Gram stain producing a Gram-negative rod can mean a lot of things. This organism could be an enteric Gram-negative rod, Pseudomonas, or a member of the HACEK group, so the features discussed above are valuable in making a preliminary identification. Each of these groups of Gram-negative bacteria have very different empiric treatment regimens, so knowing which group is suspected can be very helpful. Susceptibility testing is not routinely performed on HACEK organisms because of their poor growth characteristics. Telling a clinician that a HACEK organism like Eikenella is suspected allows them to search for relevant literature to guide their treatment. Additionally, resistance among Pasteurella has been rarely reported, and it is susceptible to most commonly used antibiotics. Knowing the presumptive identification of these organisms ensures quick and effective treatment, and prevention of the use of unnecessary antibiotics.
Strep of the Head, Neck and Brain
The Streptococcus anginosus group includes S. anginosus, S. intermedius and S. constellatus. While the S.anginosus group are not necessarily associated with a particular patient exposure history, they are distinctive for causing abscesses. They exhibit specific characteristics in the laboratory that should make the microbiologist highly suspicious of their role in an infection. The presence of an abscess in the head, neck or brain could be suggestive of a S. anginosus infection. Although this organism lives normally in the oropharynx and gastrointestinal tract, it has a propensity for causing infections in these areas, especially the brain. This is particularly true for the pediatric population.
The Gram Stain: The Gram stain for S. anginosus does not look like any other strep. While streptococci typically display neat chains of Gram-positive cocci, S. anginosus is pleomorphic, Gram variable and sick-looking. The individual cells often appear smaller than a typical strep, and they can appear to be "chewed-up." The bottom line is that the Gram stain looks junky, and this can be the microbiologist's first clue that S. anginosus is the cause of the infection.

Growth on Solid Media: S. anginosus is a fastidious organism that grows slowly on solid media and its growth characteristics are unique and easily identifiable. The most unique aspect of this organism is the strong odor of butterscotch it creates. In fact, this odor is so strong and identifiable, the microbiologist may smell it before seeing any actual growth on the media plates. Once the organism grows on solid media, it will typically display small, dry colonies. These colonies often remind me of dandruff!

How the presumptive identification helps the clinician: Because the S. anginosus group of organisms are so fastidious, it is difficult to perform susceptibility testing. It is helpful to make the clinical team aware that susceptibility testing may not be possible for this organism so that they can search the literature for appropriate treatment choices. If the clinical team was unaware of the presence of an abscess, the identification of this organism, for example from blood culture, may give them the information necessary to perform additional testing and find the source of the infection.
Bringing it All Together
Regardless of the technology the microbiology laboratory incorporates over time, the patient's history will always be one of the most important tools we have. Knowing how to presumptively identify organisms using this tool is important, and is an effective way of helping the clinical team manage their patient appropriately. The chart below provides a summary of key pathogens and their corresponding histories and exposures.

The above represent the views of the author and does not necessarily reflect the opinion of the American Society for Microbiology.
